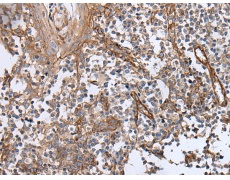
一抗

中文名稱:兔抗BLVRB多克隆抗體
|
Background: |
BLVRB (biliverdin reductase B or BVR-B), also known as flavin reductase (FR), NADPH-dependent diaphorase, Biliverdin-IX ∫-reductase or green heme-binding protien (GHBP) is an enzyme involved in fetal heme metabolism. It is dependent on NADPH and is responsible for catalyzing the transfer of electrons to flavins from reduced pyridine nucleotides. BLVRB exists as a monomer, localizes to the cytoplasm and is highly expressed in fetal liver and adult erythrocytes and, to a lesser extent, in heart, lung, cerebrum and adrenal gland. In liver, BLVRB functions to convert biliverdin (isoforms IX∫, IX and IX ) to bilirubin. BLVRB contains one binding site for all of its substrates and predominantly interacts with them through hydrophobic interactions. BLVRB also exhibits ferric reductase activity. In addition, it is commonly used as a reliable marker for NOS. |
|
Applications: |
ELISA, WB, IHC |
|
Name of antibody: |
BLVRB |
|
Immunogen: |
Synthetic peptide of human BLVRB |
|
Full name: |
biliverdin reductase B |
|
Synonyms: |
FLR; BVRB; SDR43U1; HEL-S-10 |
|
SwissProt: |
P30043 |
|
ELISA Recommended dilution: |
5000-10000 |
|
IHC positive control: |
Human tonsil and human colorectal cancer |
|
IHC Recommend dilution: |
40-200 |
|
WB Predicted band size: |
22 kDa |
|
WB Positive control: |
A549 and K562 cell lysate |
|
WB Recommended dilution: |
500-2000 |



 購(gòu)物車
購(gòu)物車 幫助
幫助
 021-54845833/15800441009
021-54845833/15800441009